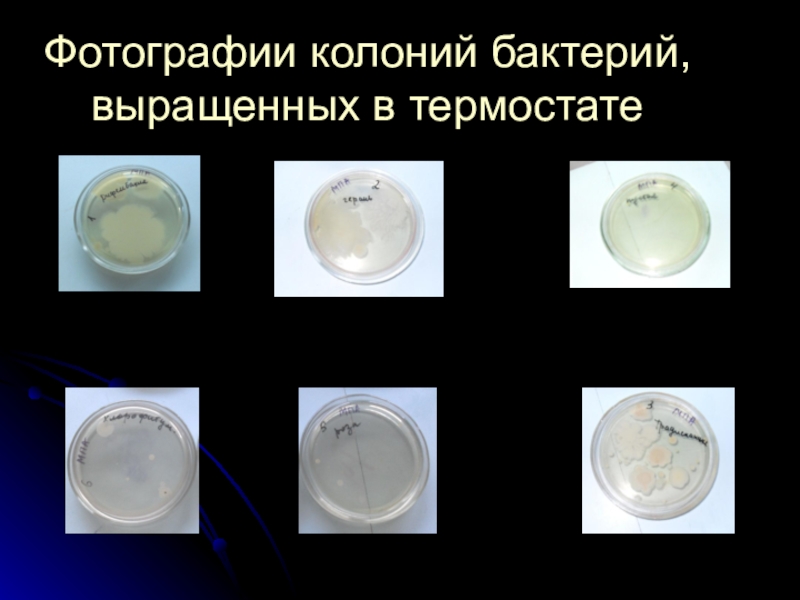

Выполнила
Ученица 8 «В» класса
Иванова Анна
МБОУ Приаргунская СОШ
Научный руководитель: Якимова Татьяна Ильинична. учитель биологии I квалификационной категории
- Главная
- Разное
- Образование
- Спорт
- Естествознание
- Природоведение
- Религиоведение
- Французский язык
- Черчение
- Английский язык
- Астрономия
- Алгебра
- Биология
- География
- Геометрия
- Детские презентации
- Информатика
- История
- Литература
- Математика
- Музыка
- МХК
- Немецкий язык
- ОБЖ
- Обществознание
- Окружающий мир
- Педагогика
- Русский язык
- Технология
- Физика
- Философия
- Химия
- Шаблоны, фоны, картинки для презентаций
- Экология
- Экономика
Презентация, доклад на тему Влияние фитонцидности растений в условиях школы на чистоту воздуха
Содержание
- 1. Влияние фитонцидности растений в условиях школы на чистоту воздуха
- 2. Актуальность Большая загруженность кабинетов не позволяет только влажной
- 3. Что такое фитонциды? Фитонциды (от греч. phytón —
- 4. Практическое применение герань Духи роза
- 5. Цель исследования Провести анализ фитонцидности имеющихся в школе
- 6. Задачи1) Провести анализ фитонцидности 5 растений.2) Выявить
- 7. Растения для экспериментаДиффенбахия
- 8. Растения для экспериментаТрадесканция Китайская
- 9. Фотографии колоний бактерий, выращенных в термостате
- 10. Влияние фитонцидов комнатных растений на окружающую среду
- 11. Измерение влажности воздуха гигрометром
- 12. Количество колоний бактерий в течении суток
- 13. Чемпион среди цветов - герань или пеларгония
- 14. Рекомендательный списокГерань, хлорофитум, бегония, диффенбахия, фикус, золотой
- 15. Практическое использование результатов исследованийРекомендуем максимально увеличить для
- 16. Заключение Наша работа несёт практическую значимость, так как
- 17. !
Актуальность Большая загруженность кабинетов не позволяет только влажной уборкой, проветриванием классной комнаты решить в полной мере вопрос чистоты воздуха. Присутствие в окружающей среде бактерий, простейших организмов, грибков вызывает заболевания, и угнетает деятельность систем организма человека. По школе
Слайд 1 «Не мало этот сад растит прелестных роз, Но тех, кто их берет,
шипы язвят до слез»
Влияние фитонцидности растений в условиях школы на чистоту воздуха.
Слайд 2Актуальность
Большая загруженность кабинетов не позволяет только влажной уборкой, проветриванием классной комнаты
решить в полной мере вопрос чистоты воздуха. Присутствие в окружающей среде бактерий, простейших организмов, грибков вызывает заболевания, и угнетает деятельность систем организма человека. По школе на первом месте среди причин пропусков занятий стоит группа заболеваний связанных с заболеванием органов дыхания ( грипп, ОРВИ, ОРЗ). Поэтому вопрос очистки воздуха является актуальным для нашей школы. Меня заинтересовал вопрос можно ли с помощью фитонцидов растений улучшить качество воздуха в школе. А заодно узнать больше о фитонцидах.
Слайд 3Что такое фитонциды?
Фитонциды (от греч. phytón — растение и лат. caedo
— убиваю) — образуемые растениями биологически активные вещества, убивающие или подавляющие рост и развитие бактерий, микроскопических грибов, простейших ( Экологический словарь).
Слайд 5Цель исследования
Провести анализ фитонцидности имеющихся в школе растений, изучить условия при
которых они максимально активны, подобрать такой состав, который бы наилучшим образом способствовал обеззараживанию воздуха.
Слайд 6Задачи
1) Провести анализ фитонцидности 5 растений.
2) Выявить условия максимальной активности фитонцидности.
3)
Подготовить рекомендательный список растений для очищения воздуха в школе.
Слайд 14Рекомендательный список
Герань,
хлорофитум,
бегония,
диффенбахия,
фикус,
золотой ус,
плющ,
драцена,
аглоонема,
циперус,
традесканция,
китайская роза,
Шефлера,
кактусы.
традесканция,
китайская роза,
Шефлера,
кактусы.
Слайд 15Практическое использование результатов исследований
Рекомендуем максимально увеличить для озеленения кабинетов и коридоров
хлорофитумы, герани и диффенбахия.
Наряду с этими растениями разводить те которые способствуют повышению влажности воздуха (монстера, циперус др.)
Продолжить эксперимент с комнатными растениями, расширив диапазон факторов воздействия на них.
При наличии финансовых возможностей организовать в школе работу кабинета аромотерапия.
Включить в план работы пришкольного участка вегетативное размножение исследуемых растений для использования их в озеленении.
Наша работа несёт практическую значимость, так как рекомендации предложенные учителям, учащимся по улучшению окружающей среды ,будут способствовать сохранению их здоровья.
Наряду с этими растениями разводить те которые способствуют повышению влажности воздуха (монстера, циперус др.)
Продолжить эксперимент с комнатными растениями, расширив диапазон факторов воздействия на них.
При наличии финансовых возможностей организовать в школе работу кабинета аромотерапия.
Включить в план работы пришкольного участка вегетативное размножение исследуемых растений для использования их в озеленении.
Наша работа несёт практическую значимость, так как рекомендации предложенные учителям, учащимся по улучшению окружающей среды ,будут способствовать сохранению их здоровья.
Слайд 16Заключение
Наша работа несёт практическую значимость, так как рекомендации предложенные учителем, учащимися
по улучшению окружающей среды будут способствовать сохранению их здоровья. Теперь мы будем знать как с помощью растений сохранить здоровье.